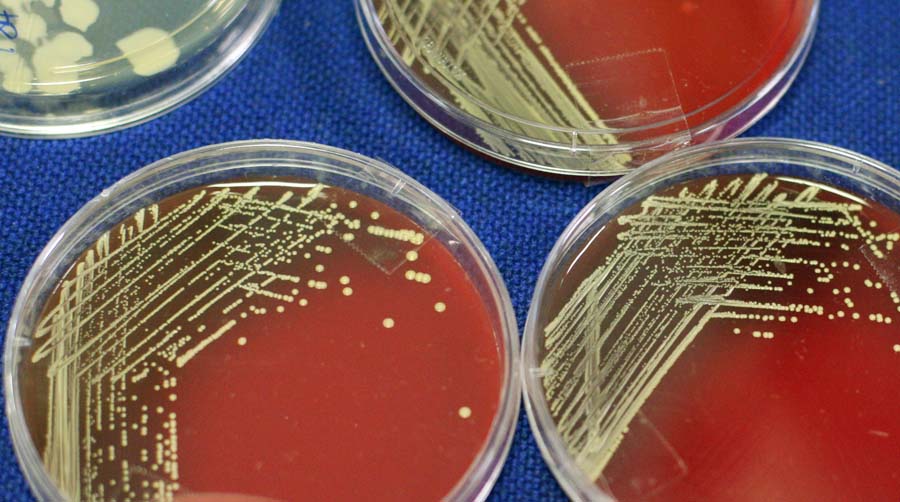

Trzydniowa konferencja (7‑9 lutego 2020 r.) naukowo-szkoleniowa poświęcona tematowi „Stare i nowe patogeny – aktualne problemy” odbyła się w Uniwersytecie Medycznym w Lublinie. Spotkanie dotyczyło zakażeń spowodowanych przez stare patogeny, które w dalszym ciągu stanowią poważny problem diagnostyczny i terapeutyczny. Sporo uwagi poświęcono także nowym, mniej znanym patogenom, które mogą również stanowić poważne problem dla życia i zdrowia ludzi.
Przewodniczącą Komitetu organizacyjnego konferencji była dr Alina M. Olender, prof. UM z Katedry i Zakładu Mikrobiologii Lekarskiej. naukowo szkoleniowa
dm (Medicus)